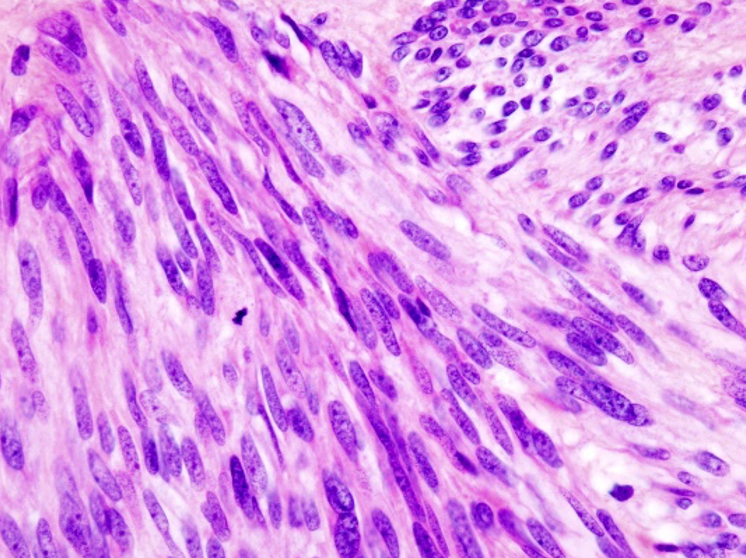

Findings in a new trial show that dietary supplementation of resistant starch has the potential to decrease people’s risk of certain types of gastrointestinal cancers.

Findings in a new trial show that dietary supplementation of resistant starch has the potential to decrease people’s risk of certain types of gastrointestinal cancers.

In clinical trials, dabrafenib and trametinib showed meaningful efficacy in multiple BRAF-positive tumor types, including in patients with rare cancers who have no other treatment options available.

Any antibiotic use was associated with higher rates of IBD, and the risk went up substantially with each course.

There is more to patients with IBD than the physical detriments, with many mental health issues arising from the condition.

Trastuzumab (Herceptin, Herzuma, Kanjinti, Ogivri, Ontruzant) is a HER2/neu receptor antagonist indicated for early and advanced breast cancer, advanced stomach cancer, and gastroesophageal junction cancer.

The research team suggests that healthy weight maintenance throughout adulthood is crucial in preventing colorectal adenoma.
Small GISTs may cause no symptoms and may grow so slowly that they have no serious effects.

The continued approval for this indication may be subject upon verification and description of clinical benefit in a confirmatory trial.

Nivolumab (Opdivo; Bristol Myers Squibb) is FDA approved for 11 cancer indications, with the most recent approval for use in combination with certain chemotherapy for the initial treatment of gastric cancer.

Primary results from the randomized portion of the INVICTUS study had previously shown that ripretinib was able to significantly improve progression-free survival with a clinically meaningful overall survival benefit in patients with advanced gastrointestinal stromal tumor.

Bemarituzumab is an investigational, potential first-in-class targeted antibody designed to block specific fibroblast growth factors from binding and activating FGFR2b.

Median disease-free survival was twice as long in patients who received nivolumab compared to patients who received a placebo.

Nivolumab is the first and only immunotherapy in combination with chemotherapy to deliver superior overall survival compared to chemotherapy alone in this patient population.

A presentation at the Community Oncology Alliance 2021 Virtual Conference focused on the latest developments in gastrointestinal oncology and how the field of gastroesophageal cancer is responding to 3 major, practice-changing trials.

The data were presented for the first time at the virtual 2021 American Association for Cancer Research (AACR) Annual Meeting, April 10-15, 2021.

Data from the FIGHT trial suggests that approximately 30% of patients with non-human epidermal growth factor 2-positive GEJ cancers overexpress fibroblast growth factor receptor 2.

The efficacy results demonstrated that there were 4 patients with confirmed partial response, and an additional 3 patients had stable disease lasting 16 weeks or longer.

The FDA approved Enhertu in January 2020 for the treatment of adult patients with unresectable or metastatic HER2-positive breast cancer.

The FDA granted priority review to a supplemental biologics license application for trastuzumab deruxtecan in patients with HER2-positive gastric or gastroesophageal junction adenocarcinoma.

Pharmacists can play an integral role in collaborating with physicians to manage patient therapy.

The FDA has granted fast track designation to DKN-01 for the treatment of patients with gastric and gastroesophageal junction adenocarcinoma whose tumors have high DKK1 expression.

Although immune checkpoint inhibitors are not yet approved for first-line therapy in these populations, the new research could lead to a new standard of care.

Patients should be selected for therapy based on the FDA approved companion diagnostic for a trastuzumab product.

Trastuzumab-dttb was first approved in January 2019 across all eligible indications, mainly adjuvant treatment of HER2-overexpressing breast cancer, metastatic breast cancer, and metastatic gastric cancer.

Trastuzumab is indicated for the treatment of human epidermal growth factor receptor-2 (HER2) overexpressing breast cancer and HER2 overexpressing metastatic gastric or gastroesophageal junction adenocarcinoma.